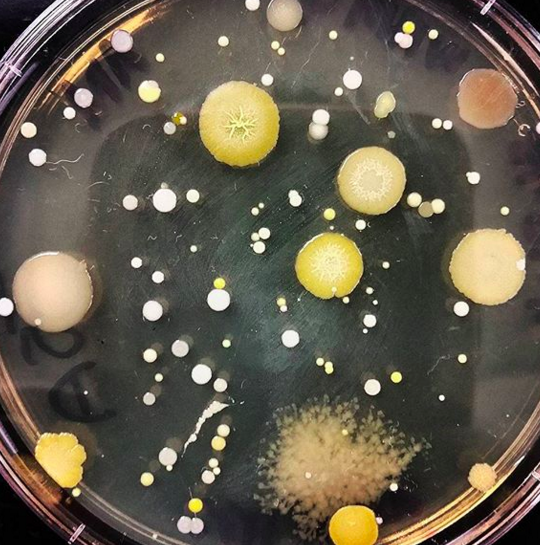
Photo

现代人几乎都离不开手机,带智慧型手机去厕所打发时间也是常态。上厕所时人们不是忙着回简讯、看网页,就是检查FB或Instagram有几个讚,这个习惯其实有许多隐忧!如果可以改掉一边蹲厕所,一边玩手机的习惯,就能改善你的健康喔!
▼现在许多人去厕所忘记带手机,就会是以下这种表情…
「唉,要怎幺度过便便的时间呢?」

仔细想想,在厕所里玩手机真的很不卫生!美国亚历桑纳大学的微生物学教授查理(Charles Gerba),和环境健康副教授凯莉(Kelly Reynolds)都指出:在浴厕使用手机有致病风险。
▼查理说明,手机上的微生物或细菌会令人生病!而这些细菌和微生物来自粪便!

▼厕所里被细菌和微生物污染最严重的是把手、门、水龙头和地板 。研究指出,有些皮包之所以会有粪便微粒,25%的原因是因为放在浴厕的地板上。

▼副教授凯莉说明,沖马桶时,粪便、水、尿液的悬浮微粒会朝着「每一个」方向喷出,最远可以喷到1.8米!更可怕的是这些悬浮微粒会随着每次沖水累积!若在公厕,公厕所附的卫生纸将会充满了这些噁心的微粒,而你带进去的手机也是一样的道理。

▼凯莉说:「这些悬浮微粒会传播,因此每次将手机放置在厕所时,就会被病菌和排泄物汙染。」无论是大肠桿菌、诺罗病毒、沙门氏菌、甲型肝炎、耐甲氧西林金黄色葡萄球菌、及急性肠胃炎等,都可能在公厕里感染。就算如厕后已经洗手,但若一触摸到曾带进厕所里的手机,就等同于没洗过手啊!
▼不只刚才所说的那些病菌令人生病,就算你自己洗过手,还是无法确保是否每一个人如厕后都会洗。当你触摸门把时,就可能接触到这些病菌和微生物!尤其在美国,诺罗病毒是酿成成人腹泻的主因,得病原因自然是不够卫生的生活习惯!

看完这篇文章,才知道原来带手机进厕所是风险多高的一件事。下次上厕所别再玩手机了,小心滑出一堆细菌或粪便。如果感染肠胃炎或吃进其他病菌就得不偿失了!赶快把这篇文章分享出去,让更多人知道吧。





